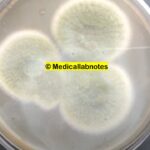
A. fumigatus: Introduction, Morphology, Pathogenicity, Lab Diagnosis, Treatment, Prevention, and Keynotes

Tag: Antifungal resistance
Fungal Identification by Artificial Intelligence (AI): Introduction, Working Mechanisms, Clinical Significance, and Keynotes
 Introduction of Fungal Identification by Artificial Intelligence (AI) Fungal infections represent...
Introduction of Fungal Identification by Artificial Intelligence (AI) Fungal infections represent...
Prototheca: Introduction, Morphology, Pathogenicity, Lab Diagnosis, Treatment, Prevention, and Keynotes
 Introduction Prototheca is an achlorophyllic alga that causes opportunistic infections....
Introduction Prototheca is an achlorophyllic alga that causes opportunistic infections....
A. fumigatus: Introduction, Morphology, Pathogenicity, Lab Diagnosis, Treatment, Prevention, and Keynotes
Introduction Aspergillus fumigatus is a filamentous fungus that belongs to...
Introduction Aspergillus fumigatus is a filamentous fungus that belongs to...
